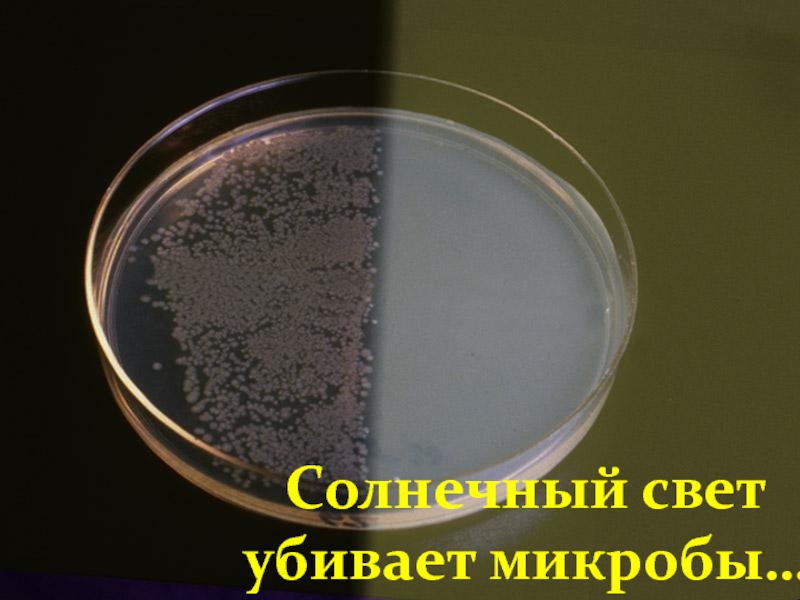

- Главная
- Разное
- Образование
- Спорт
- Естествознание
- Природоведение
- Религиоведение
- Французский язык
- Черчение
- Английский язык
- Астрономия
- Алгебра
- Биология
- География
- Геометрия
- Детские презентации
- Информатика
- История
- Литература
- Математика
- Музыка
- МХК
- Немецкий язык
- ОБЖ
- Обществознание
- Окружающий мир
- Педагогика
- Русский язык
- Технология
- Физика
- Философия
- Химия
- Шаблоны, фоны, картинки для презентаций
- Экология
- Экономика
Презентация, доклад по ЗОЖ 6 ключей к здоровью для детей старшего дошкольного возраста
Содержание
- 1. Презентация по ЗОЖ 6 ключей к здоровью для детей старшего дошкольного возраста
- 2. Ключ первый:вода
- 3. Мы состоим из водыНа 70-80%
- 4. КАК ОРГАНИЗМ ТЕРЯЕТ ВОДУ?Дыхание ...500 мл/деньС потом
- 5. Поэтому необходимо выпивать 8 - 10 стаканов воды в день
- 6. ЧТО является лучшим напитком?
- 7. Вода – это лучший напиток!
- 8. Состоим мы из воды.Чтобы не было
- 9. Ключ второй:воздух
- 10. Для жизни нужен воздух, а для здоровья – свежий воздух
- 11. несколько недель без еды несколько дней
- 12. Неправильное дыхание
- 13. Голова поднятаСпина прямая Плечи развернуты Грудь высокая Живот подтянут Хорошая осанкапомогает глубоко дышать
- 14. Правильное дыханиеобеспечивает необходимуювентиляцию легких
- 15. Кислородные ванны
- 16. Ключ третий:солнце
- 17. Солнечные лучи являются благотворными для здоровья
- 18. Солнечный свет убивает микробы…
- 19. Поднимает настроениеУкрепляет иммунитетУлучшает сонСпособствует выработке витамина DДелает кожу мягкой, гладкойСнимает боль
- 20. Белому человеку достаточно 5 минут в
- 21. Но…Старайтесь не обгорать.Ожоги разрушают кожу.
- 22. Ключ четвёртый:Физические упражнения
- 23. Движение – это жизнь Жизнь – это движение
- 24. Физические упражненияПомогают поддерживать тело здоровым.
- 25. Физические упражнения:Улучшают самочувствиеУкрепляют костиПовышают работоспособностьУлучшают сонУкрепляют здоровьеКонтролируют вес
- 26. Ключ пятый:питание
- 27. Питание - это строительный материал нашего организма
- 28. Правила питания Питайтесь регулярно.Употребляйте только
- 29. С помощью этой пирамиды, вы сможете увидеть, какие продукты являются самыми полезными.
- 30. Разнообразие продуктов – ключ к правильному питанию
- 31. Ключ шестой:отдых
- 32. он восстанавливает силыдаёт время и возможность организму восстановить то, что было им потраченоНам нужен отдых !
- 33. Отдыхайте5 мин в час1час в день1 день в неделю1 месяц в году
- 34. Регулярный и полноценный соннужен нам для ухода и заботы о нашем организме
- 35. 6-летние дети спят по 10 часов
- 36. Постоянное время для сна
- 37. 6 ключей к здоровью:1 вода2 воздух3 солнце4 физические упражнения5 питание6 отдых
Ключ первый:вода
Слайд 4КАК ОРГАНИЗМ ТЕРЯЕТ ВОДУ?
Дыхание ...500 мл/день
С потом ..300 мл/день
Стул …..200
мл/день
Моча…..500-1500 мл/день
Всего 1500 - 2500 мл/день-это
10-12 стаканов
Слайд 8
Состоим мы из воды.
Чтобы не было беды,
То хотя бы 6 стаканов
Надо
пить: 2 утром рано,
2 стакана до обеда,
2 до ужина испить.
Это станет вашим кредо,
Золотая жизни нить.
Если жажда вас гнетёт
Кока-кола не спасёт.
Организму ведь не надо
«Фанты» или лимонада
Кто с водою чистой дружен,
Тому врач совсем не нужен!
2 стакана до обеда,
2 до ужина испить.
Это станет вашим кредо,
Золотая жизни нить.
Если жажда вас гнетёт
Кока-кола не спасёт.
Организму ведь не надо
«Фанты» или лимонада
Кто с водою чистой дружен,
Тому врач совсем не нужен!
Слайд 11 несколько недель без еды
несколько дней без воды
но только
несколько минут без воздуха
Человек
может прожить
Слайд 13Голова поднята
Спина прямая
Плечи развернуты
Грудь высокая
Живот подтянут
Хорошая осанка
помогает
глубоко дышать
Слайд 14Правильное
дыхание
обеспечивает необходимую
вентиляцию легких
и способствует снижению риска
инфекционных заболеваний
инфекционных заболеваний
Слайд 19Поднимает настроение
Укрепляет иммунитет
Улучшает сон
Способствует выработке витамина D
Делает кожу мягкой, гладкой
Снимает боль
Слайд 20Белому человеку
достаточно 5 минут
в день находиться
на солнце для
получения витаминаD
требуется в 6 раз дольше находиться на солнце, чтобы получить ту же дозу витамина D.
Темнокожему человеку
Слайд 25Физические упражнения:
Улучшают самочувствие
Укрепляют кости
Повышают работоспособность
Улучшают сон
Укрепляют здоровье
Контролируют вес
Слайд 28
Правила питания
Питайтесь регулярно.
Употребляйте только
полезную
пищу.
Соблюдайте режим,
ешьте в одно и то же время.
Не перекусывайте
между едой
Соблюдайте режим,
ешьте в одно и то же время.
Не перекусывайте
между едой
Слайд 30Разнообразие продуктов –
ключ к правильному питанию
Выбор в пользу фруктов,
овощей и продуктов из цельного зерна защищает наше здоровье
Чем ярче и насыщеннее цвета продуктов, тем сильнее их защитные свойства
Чем ярче и насыщеннее цвета продуктов, тем сильнее их защитные свойства
Слайд 32он восстанавливает силы
даёт время и возможность организму восстановить то, что было
им потрачено
Нам нужен отдых !